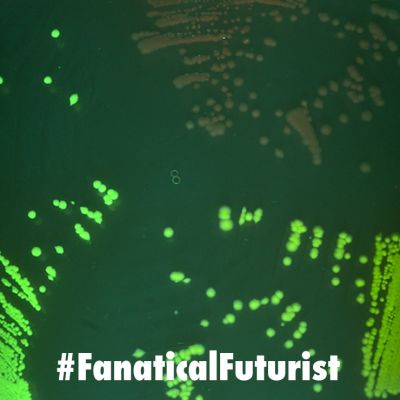

Industrial Revolution
WHY THIS MATTERS IN BRIEF Display systems are everywhere, but this latest innovation oushes the limits of biology, technology, and imagination … Love the…
WHY THIS MATTERS IN BRIEF Compounds are the basis for all materials on Earth, and the invention of a new family of compounds is a…
WHY THIS MATTERS IN BRIEF Magnetorestrictive materials might not be commonplace, but now they’re helping China’s latest generation of stealth submarines become undetectable at sea….
WHY THIS MATTERS IN BRIEF Everything is made of compounds and materials, and by discovering and inventing almost 400,000 new ones this news could revolutionise…
WHY THIS MATTERS IN BRIEF When it comes to making big things humanity’s great, but we’re getting better at creating things at the nanoscale too…
WHY THIS MATTERS IN BRIEF Industry 4.0 was about AI, automation, IOT, and was tech-centric, Industry 5.0 is human-centric and promotes more ethical and responsible…
WHY THIS MATTERS IN BRIEF At 5 million fps you can record the movement of individual molecules, and change science – and other stuff. …
WHY THIS MATTERS IN BRIEF By imposing a tax on the amount of carbon used to manufacture products that the EU imports from other countries…
WHY THIS MATTERS IN BRIEF What is buildings could regenerate the environment and leave nothing behind when they’re gone? Love the Exponential Future? Join…
WHY THIS MATTERS IN BRIEF Many people query the ethics of using foetal bovine serum to grow lab based meats, but this new synthetic protein…
WHY THIS MATTERS IN BRIEF Nature and synthetic biology are finding new ways to combat humanity’s waste and pollution problems. Love the Exponential Future?…
WHY THIS MATTERS IN BRIEF Not everything man made is better than what nature can create, although increasingly using synthetic biology we’re re-creating nature. …